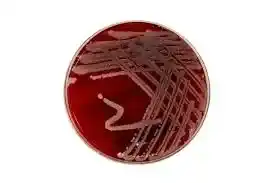

کاربرد محیط کشت ایکس ال دی آگار (Xylose Lysine Deoxycholate Agar) یک محیط کشت افتراقی و انتخابی است که به طور گسترده در شناسایی و جداسازی باکتریهای گرم منفی رودهای مورد استفاده قرار میگیرد. این محیط کشت بهویژه برای تشخیص باکتریهای سالمونلا و شیگلا طراحی شده است. ترکیبات اصلی این محیط شامل زایلوز، لیزین، دکستروز، تیوسولفات سدیم، و فنول رد است.
شرکت دانش پژوهان شیمی وارد کننده اصلی مواد شیمیایی آزمایشگاهی بخصوص برند مرک آلمان و سیگماآلدریچ در ایران می باشد. جهت خرید محیط کشت می توانید با همکاران این مجموعه تماس حاصل نمائید.
محیط کشت بلاد آگار کد110886 محیطی جامد و مغذی با 5% خون گوسفند است و برای شناسایی باکتری هایی به کار می رود، که به واسطه آنزیم هایی که تولید می کنند باعث لیز شدن گلبولهای قرمز می شود و این فرایند همولیز نامیده می شود. محیط بلاد آگار محیطی غنی شدهبرای رشد باکتری های سخت رشد مانند streptococci که بر روی محیط های کشت روتین رشد نمیکنند.محیط کشت بلاد آگار برای رشد طیف وسیعی از پاتوژن های سخت رشد مانند Haemophilus influenzae , Streptococcus pneumoniae , Neisseria به کار می رود.

مقدمه
محیط کشت ایکس ال دی آگار (Xylose Lysine Deoxycholate Agar) یکی از ابزارهای مهم و کاربردی در تشخیص و شناسایی باکتریهای بیماریزا بهویژه سالمونلا و شیگلا است. در این مقاله، به بررسی ویژگیها، کاربردها و نحوه استفاده از این محیط کشت خواهیم پرداخت. کاربرد محیط کشت ایکس ال دی آگار
زایلوز بهعنوان منبع قند عمل میکند و تخمیر آن توسط باکتریها باعث تغییر رنگ محیط میشود. لیزین بهعنوان یک اسید آمینه، در متابولیسم باکتریها نقش دارد و تغییرات آن میتواند به شناسایی باکتری کمک کند. دکستروز نیز منبع دیگری از قند است که در این محیط کشت استفاده میشود. تیوسولفات سدیم بهعنوان عامل تشخیص سولفید هیدروژن عمل میکند که تولید آن باعث تشکیل رسوب سیاه رنگ میشود. فنول رد بهعنوان شاخص pH در این محیط کشت بهکار میرود و تغییرات pH محیط را با تغییر رنگ نشان میدهد. کاربرد محیط کشت ایکس ال دی آگار
محیط کشت ایکس ال دی آگار با داشتن این ترکیبات خاص، قابلیت تشخیص و جداسازی دقیق باکتریهای مختلف را فراهم میکند. این محیط کشت به دلیل ویژگیهای منحصر بهفرد خود بهعنوان یکی از استانداردهای طلایی در آزمایشگاههای میکروبیولوژی شناخته میشود. کاربرد محیط کشت ایکس ال دی آگار
محیط کشت ایکس ال دی آگار یک محیط کشت انتخابی و افتراقی است که برای شناسایی و جداسازی باکتریهای گرم منفی رودهای بهویژه سالمونلا و شیگلا مورد استفاده قرار میگیرد. کاربرد محیط کشت ایکس ال دی آگار
محیط کشت ایکس ال دی آگار برای اولین بار در دهه ۱۹۶۰ معرفی شد و به سرعت به عنوان یکی از ابزارهای استاندارد در آزمایشگاههای میکروبیولوژی پذیرفته شد. کاربرد محیط کشت ایکس ال دی آگار

محیط کشت ایکس ال دی آگار شامل ترکیبات مختلفی است که هر یک نقش خاصی در تشخیص و شناسایی باکتریها دارند.
آگار بهعنوان ماده جامدکننده در محیط کشت ایکس ال دی آگار استفاده میشود و به ایجاد سطحی ثابت برای رشد باکتریها کمک میکند. کاربرد محیط کشت ایکس ال دی آگار
زایلوز بهعنوان یکی از منابع قند در محیط کشت ایکس ال دی آگار عمل میکند و تخمیر آن توسط باکتریها منجر به تغییر رنگ محیط میشود. کاربرد محیط کشت ایکس ال دی آگار
لیزین بهعنوان یک اسید آمینه در محیط کشت ایکس ال دی آگار وجود دارد و تخریب آن توسط باکتریها میتواند نشانهای از ویژگیهای متابولیکی خاص باشد. کاربرد محیط کشت ایکس ال دی آگار
دکستروز بهعنوان منبع قند دیگری در محیط کشت ایکس ال دی آگار استفاده میشود و تخمیر آن نیز میتواند به شناسایی باکتریها کمک کند. کاربرد محیط کشت ایکس ال دی آگار
تیوسولفات سدیم بهعنوان یک عامل تشخیص سولفید هیدروژن در محیط کشت ایکس ال دی آگار عمل میکند.
فنول رد بهعنوان شاخص pH در محیط کشت ایکس ال دی آگار عمل میکند و تغییرات رنگ آن نشاندهنده تغییرات pH محیط است. کاربرد محیط کشت ایکس ال دی آگار
شرکت دانش پژوهان شیمی که نمایندگی مرک آلمان و نمایندگی سیگماآلدریچ در ایران، با همکاری کارشناسان مجرب خود در بخش فنی و فروش، جهت تامین مواد اولیه پژوهش های تحقیقاتی ماده های با کیفیت بالا و قیمت مناسب را فراهم نموده است. شما می توانید جهت خرید محیط کشت ایکس ال دی آگار با بخش فروش شرکت دانش پژوهان شیمی تماس حاصل بفرمایید و پس از دریافت پیش فاکتور و اطمینان حاصل نمودن از صحت نام محصول، کد، شماره CAS نامبر مواد شیمیایی درخواستی اقدام به ثبت سفارش نمایید تحویل کالاهای خریداری شده و زمان تحویل آنها به صورت زیر می باشد.
زمان ارسال سفارشات از انبار: ۲۴ تا ۴۸ ساعت کاری می باشد
نحوه ارسال کالای مشتریان: تهران توسط پیک
تغییرات pH در محیط کشت ایکس ال دی آگار بهواسطه تخمیر قندها توسط باکتریها منجر به تغییر رنگ محیط میشود که میتواند به شناسایی نوع باکتری کمک کند.
محیط کشت ایکس ال دی آگار دارای قابلیت تشخیص تولید گاز توسط باکتریها است. تولید گاز باعث تشکیل حبابها یا ترکهایی در محیط کشت میشود که میتواند نشانهای از فعالیت متابولیکی باکتریها باشد.
یکی از ویژگیهای منحصر بهفرد محیط کشت ایکس ال دی آگار قابلیت تشخیص سولفید هیدروژن است. تولید این ماده توسط باکتریها باعث ایجاد رسوب سیاه رنگ در محیط کشت میشود.
مواد لازم
برای تهیه محیط کشت ایکس ال دی آگار به مواد زیر نیاز داریم:
مراحل تهیه
مزایا
معایب
محیط کشت ایکس ال دی آگار در مقایسه با سایر محیط کشتهای باکتریولوژیکی دارای مزایا و معایب خاص خود است. این محیط کشت بهطور ویژهای برای شناسایی سالمونلا و شیگلا طراحی شده است و از این رو در برخی موارد بهتر از محیط کشتهای دیگر عمل میکند.

نمونههای مورد استفاده در محیط کشت ایکس ال دی آگار
محیط کشت ایکس ال دی آگار برای شناسایی انواع مختلفی از باکتریها از جمله سالمونلا و شیگلا مورد استفاده قرار میگیرد. کاربرد محیط کشت ایکس ال دی آگار
برخی مشکلات رایج در استفاده از محیط کشت ایکس ال دی آگار شامل آلودگی محیط کشت، تغییرات غیرمنتظره در رنگ، و عدم رشد باکتریها است. برای حل این مشکلات باید از استریلیزاسیون مناسب، تهیه دقیق محلول، و رعایت نکات بهداشتی استفاده کنید. کاربرد محیط کشت ایکس ال دی آگار
شرکت دانش پژوهان شیمی یکی از بزرگترین وارد کنندگان و فروشندگان مواد شیمیایی و آزمایشگاهی بخصوص فروش محیط کشت ایکس ال دی آگار می باشد. این شرکت در زمینه واردات این محصولات از تجربه بسیار بالایی برخوردار است. شما می توانید جهت تهیه این محصولات (اصلی) با بخش فروش شرکت تماس گرفته و با کارشناسان این شرکت در ارتباط باشید و یا از طریق کانال واتساپ شرکت نام محصول به همراه میزان نیاز خود را ارسال تا در کمترین زمان پاسخ استعلام خود را دریافت نمائید.امیدواریم بتوانیم با ارائه محصولات اصلی و با بهترین کیفیت شما را برای رسیدن به اهدافتان یاری نمائیم.
جهت محصولات بیشتر واستعلام سریع قیمت محیط کشت ایکس ال دی آگار میتوانید از طریق کانال واتساپ شرکت با ارسال نام ماده و مقدار نیاز در کمترین زمان پاسخ استعلام خود را دریافت نمائید.
راههای ارتباطی
شماره های تماس:
021-66859216
021-66859220 (ساعات تماس:8.30 الی 19)
واتساپ:09129618292 (24ساعت)
Last Updated on 08/01/2024 by adminm